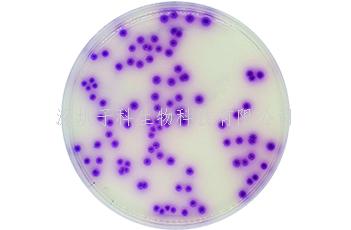

热门关键词: ELISA试剂盒 - 大鼠ELISA试剂盒- 小鼠ELISA试剂盒
全国统一客服热线:
0755-28715175
热门关键词: ELISA试剂盒 - 大鼠ELISA试剂盒- 小鼠ELISA试剂盒
全国统一客服热线:
0755-28715175

应用:用于临床样品和食品中沙门氏菌的分离。
琼脂 12.8g/L; 蛋白胨和牛肉膏 5g/L; 色素 5.81g/L; 柠檬酸钠 8.5g/L
PH 值: 7.2±0.2
3.加热后的培养基冷却至 45-50ºC,轻轻地摇动均匀,倾注平皿,使其凝固,晾干备用。
保存: 该成品平板在室温可保存一天或在冰箱内储存 2 周(2-8ºC,避光)。
接种: 划线或涂布接种(冰箱内保存的平板使用前应恢复至室温)。
培养: (35±2ºC / 18-24 h)。
落颜色相同的假单胞菌。
贮存条件: 干粉需保存于 15-25ºC,在有效期前使用。
使用过的培养基需要在 121ºC 灭菌至少 20 分钟才可以按照有关规定丢弃。
0755-28715175/33164177

粤公网安备 44030902000304号